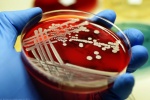

Папилломовирусная инфекция при беременности
Вирус папилломы человека очень распространен: около 90% населения мира являются его носителями. Заражение может произойти половым, контактно-бытовым путем или во время родов. Долгое время заболевание может никак не проявляться, но у женщины наступает беременность, и папиллома переходит в стадию обострения. Новообразования чаще появляются на коже шеи, щек, груди, подмышек и в паховой области.

Папиллома – название целой группы вирусов. Поэтому, чтобы ответить на вопрос о ее опасности во время беременности, необходимо определить тип и локализацию. Порой инфекция не представляет никакой угрозы для ребенка, в иногда требует лечения.
Папилломавирусная инфекция при беременности
Папилломовирусная инфекция долгое время может протекать в скрытой форме. Обострения происходят при снижении иммунитета, например, во время беременности. По данным статистики, около 80% будущих мам обнаруживают у себя на коже папилломы. Внешне высыпания такие же, как и у всех остальных людей: телесного цвета или чуть темнее, округлой формы, часто на ножке. Но в этот период они появляются более масштабно и быстро.
Новообразования сами по себе безболезненны, но неэстетичны, поэтому многие женщины хотят их как можно быстрее устранить. Вирус папилломы человека может быть неонкогенным и онкогенным, с низким или высоким риском перерождения в раковую опухоль.
Для того чтобы выяснить к какому типу относятся высыпания, необходимо провести лабораторную диагностику.
Дискомфорт доставляют папилломы, расположенные в местах соприкосновения с краем или швом одежды, а также на сгибах конечностей. В этих случаях существует вероятность их повреждения и развития кровотечения.
Особенно хрупки кондиломы – похожие на бородавки наросты, которые крепятся к поверхности при помощи тонкой ножки. Часто они обнаруживаются на гениталиях и могут вызвать чувство дискомфорта, зуд, сукровичные или желто-зеленые влагалищные выделения.
Влияние на организм беременной и плод
Так как папилломы являются вирусным заболеванием, многих женщин беспокоит их возможное влияние на внутриутробное развитие плода и течение беременности в целом. Если новообразования расположены не на гениталиях, то никакой опасности они не представляют.
Когда папилломы расположены на половых органах, то рост высыпаний ускоряется, увеличивается риск повреждения и кровотечения. Также появляются влагалищные выделения – влажная среда, идеальная для размножения ВПЧ и других возбудителей инфекций. На фоне этого могут происходить нарушения гормонального фона и снижение иммунитета. Подробнее о том, как укрепить иммунитет во время беременности →

В редких случаях генитальные папилломы могут передаться ребенку во время родов. Часто организм младенца справляется самостоятельно и заболевание переходит в бессимптомную фазу, не представляющую опасности. Иногда после заражения у малыша развиваются новообразования на голосовых связках (папилломатоз дыхательных путей) или в других местах. Такие состояния опасны и требуют лечения, но встречаются крайне редко.
Причины
У будущих мам высыпания на коже появляются быстро и нередко покрывают большие участки кожи. Причины обострения папилломовирусной инфекции при беременности следующие:
- естественное снижение иммунитета, необходимое для успешного вынашивания ребенка;
- обострение некоторых хронических болезней;
- гормональные изменения, которые вызывают изменения в верхних слоях кожи;
- более частые повреждения кожных покровов, которые связаны с увеличением веса женщины, а также с иммунными и эндокринными изменениями;
- сахарный диабет, обостряющийся на фоне гормональных всплесков.
Диагностика
Выявлением папилломовирусной инфекции у беременной занимается дерматолог или венеролог. Каждый тип вируса проявляется по-своему. Основываясь на данных осмотра, можно установить диагноз только в случае остроконечных кондилом. Однако определить их тип и степень онкогенности без лабораторных методов исследования нельзя.
Основной метод диагностики при папилломовирусной инфекции – анализ методом ПЦР. Для получения материала врач делает соскоб из шейки матки (реже – из уретры). Суть метода в том, что под действием специальных ферментов количество ДНК вируса в образце увеличивается в геометрической прогрессии. После этого инфекцию легче увидеть при помощи микроскопа.
ПЦР-диагностика помогает обнаружить вирус папилломы человека, установить к какому типу он относится, насколько онкогенен, а также дать его количественную оценку. Сочетание этих параметров значимо, оно помогает определить, когда произошло заражение, а значит и тех людей, которые являлись переносчиками и нуждаются в лечении.
В некоторых случаях для получения более точной информации об особенностях строения ткани и правильности расположения слоев назначается биопсия. Данные гистологического анализа позволяют судить о стадии заболевания и риске перерождения образований в онкологические.
Лечение
Если у женщины выявлена беременность и папиллома, в зависимости от того, насколько опасен вирус, лечение может быть проведено с 28-й недели гестации или отложено до окончания процесса вынашивания. При локализации высыпаний у будущей мамы в местах, где часто происходит травмирование кожи, папилломы нужно удалить.
Для этого может быть применено хирургическое иссечение с местной заморозкой кожных покровов, криодеструкция, лазерная обработка, электрокоагуляция. Но стоит помнить, что большая часть папиллом исчезает самостоятельно после родов, поэтому такое вмешательство – крайняя мера, необходимая при разрастании генитальных кондилом.

С 28-й недели у плода уже сформированы все органы и плацента частично защищает его от вредных веществ, поступающих с кровью матери. С этого периода возможно применение лекарственных средств. Местно используются мази и гели: Виферон, Солкодерм, Ацикловир, Оксолиновая мазь. Внутрь назначаются лекарства с иммуномодулирующим действием: Кипферон, Анаферон, Реаферон, Виферон.
Лечение папилломовирусной инфекции лучше всего проводить до беременности. Это поможет избежать дискомфорта и лишних переживаний в столь ответственный период.
Осложнения
Наиболее опасное осложнение папилломовирусной инфекции – рак шейки матки, влагалища или вульвы. Более чем из 30 видов генитальных ВПЧ, 15 являются онкогенными. В 70% случаев причиной злокачественной опухоли становятся вирусы 16 и 18 типа.
Кроме онкологических заболеваний, без своевременного лечения папилломы могут стать источником инфекции. Например, кондиломы, разрастаясь, начинают гноиться и кровоточить, в результате чего слизистая покрывается изъязвлениями. Гной вместе с кровью способствуют распространению воспалительного инфекционного процесса. Снижается иммунитет, происходит обострение хронических заболеваний различных органов.
При беременности выраженное разрастание генитальных папиллом может препятствовать естественному процессу родов. В таких случаях проводится кесарево сечение. Риск осложнений у ребенка низок. Изредка заражение происходит при прохождении через родовые пути, заболевание проявляется у младенца папилломами в дыхательных путях, а также на гениталиях, анусе, шеи и подмышках.
Профилактика
Несмотря на то, что основной путь передачи инфекции половой, презервативы не защищают от заражения. Вакцина от папилломовирусной инфекции находится в стадии разработки. Поэтому профилактика основывается на поддержании активности иммунной системы: прогулки на свежем воздухе, сбалансированное питание, прием витаминно-минеральных комплексов и т.д.
Также, с целью предупреждения высыпаний, беременной нужно следить за набором веса и носить удобное нижнее белье из натуральной ткани, чтобы избежать раздражения паховой области. Если папилломы при беременности все же появились, то стоит как можно быстрее сообщить об этом врачу и обсудить с ним необходимость лечения.
Беременность и папилломовирусная инфекция часто протекают одновременно. Обострение заболевания провоцируется снижением иммунитета, гормональными изменениями, набором веса. В большинстве случаев оно не требует лечения, так как не представляет угрозы для плода и процесса вынашивания. Но если высыпания доставляют дискомфорт, то применяются местные противовирусные средства, иммуномодулирующие препараты, а также практикуется удаление папиллом хирургическим путем.
Автор: Ольга Ханова, врач,
специально для Mama96.ru
Полезное видео: планирование беременности при папилломовирусной инфекции

Прывітанне, я пакутаваў як ВІЧ-пацыент столькі гадоў, але мяне вылечыў лекар-травянік з Індыі, і я ўбачыў яго паведамленне на старонцы навін у ЗША. Я ведаю, што многім людзям цікава, як мне ўдаецца здабыць такое, бо так шмат расейцаў не ведаюць, але ёсць і шмат аферыстаў. першапачаткова мяне падманулі невядомыя Доктар, і я амаль страціў упэўненасць, але я даў доктару Раджыву шанец, і ён змог мяне выратаваць. Пасля таго, як я вылечылася, я ўсё яшчэ сумняваюся, што нешта ўва мне было. Я пайшоў у Медыцынскую лабараторыю, тады я выпрабаваў негатыў, і я быў такі шчаслівы. для атрымання дадатковай інфармацыі звяжыцеся з лекарам па гэтай электроннай пошце: viruses.diseases.cure@gmail.com
У многих впч, это не так страшно. Мне кажется, что он обычный спутник. У меня знакомая рожала с ним. Все хорошо! Лечилась эпигеном, потом разные препараты для флоры и все Ок.
Бородавки — это тоже ВПЧ, у него уже выявлено больше 600 штаммов. Никакие «фероны» ВПЧ не лечат, от него вообще нет специфического лечения. Единственный пока что способ уберечься — это профилактика вакцинами, Церварикс или Гардасил, у нас в России в некоторых регионах Гардасилом даже бесплатно прививают.